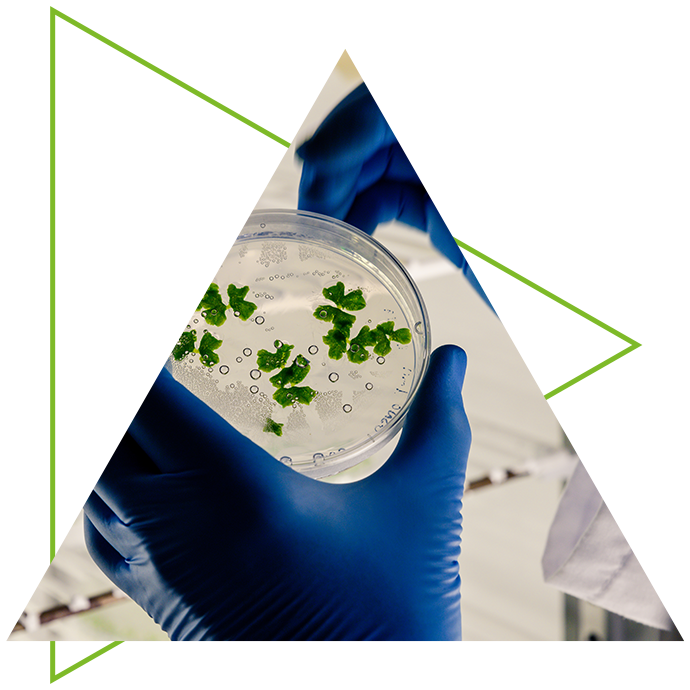

Una oferta integral,
en un solo lugar
Somos los distribuidores de químicos y materias primas más seguros de Colombia.
Síguenos:
DESEAMOS SER SU
MEJOR ELECCIÓN
DESEAMOS SER SU MEJOR ELECCIÓN
Sin importar lo que necesite, nosotros evaluamos su necesidad y presupuesto, de esta forma le brindamos diversos productos que se acomodan a sus necesidades, contamos con un equipo para ayudarle a tiempo y dentro del presupuesto. No dude en contactarnos para solicitar una cotización, siempre estaremos encantados de contestar sus preguntas y le prometemos que no quedará decepcionado.
Una oferta integral
para su empresa
Una oferta integral para su empresa
Beneficios Delta

Productos importados y legalizados.

Financiación comercial y amplio conocimiento del mercado.

Salud y seguridad en nuestros productos, cumpliendo con estándares internacionales.

Calidad en cada despacho, con entregas ágiles, optimizando sus tiempos.

Rápida atención al cliente.

Una oferta competitiva frente al mercado, con mejores precios y alta calidad.

Mantenemos su producción en funcionamiento en cualquier momento y en cualquier lugar.

Entregamos cumpliendo con sus certificados y hojas de seguridad.

El suministro más fiable y flexible del mercado.
Beneficios Delta

Productos importados y legalizados.

Rápida atención al cliente.

Financiación comercial y amplio conocimiento del mercado.

Calidad en cada despacho, con entregas ágiles, optimizando sus tiempos.

Una oferta competitiva frente al mercado, con mejores precios y alta calidad.

Mantenemos su producción en funcionamiento en cualquier momento y en cualquier lugar.

Entregamos cumpliendo con sus certificados y hojas de seguridad.

El suministro más fiable y flexible del mercado.

Salud y seguridad en nuestros productos, cumpliendo con estándares internacionales.
Adquiera nuestros productos en 3 simples pasos

2° Paso
Diligencie sus datos para coordinar su pedido.

3° Paso
Realice el proceso de pago para generar la entrega en el lugar y hora que nos indique.

¿Presenta alguna emergencia?
Cuente con nuestro servicio de atención al cliente 24/7, disponible para atender algún hecho inesperado relacionado con nuestros productos.
Preguntas frecuentes
Aquí encontrará las preguntas más frecuentes de nuestros clientes sobre cómo pedir un producto, la tramitación de su pedido y la seguridad de la información. Si no encuentra algo relacionado con su necesidad, comuníquese con nosotros y le contactaremos en breve.
Si necesita cambiar o cancelar un pedido, por favor contáctenos antes de ser despachado, desde nuestros canales de información o al correo electrónico quimdel@hotmail.com para darle respuesta a su solicitud.
Una vez haya realizado un pedido, recibirá inmediatamente un correo electrónico de respuesta. La factura también llegará directamente a su correo.
Contamos con un equipo especializado para brindarle asesoría personalizada de acuerdo a su necesidad.Comuníquese con nosotros desde nuestros canales de atención.
Puede solicitar cualquier documento que sea relevante para su negocio. Solo tiene que hacer clic en el botón de WhatsApp o por vía correo se le enviará todo lo solicitado.
Díganos cómo podemos ayudarle. Estamos aquí para asegurarnos de que cualquier inquietud sea resuelta sin problema, contáctenos y le responderemos lo antes posible.

3102414212

Dirección
Carrera 67a #12A - 48

Correo Electrónico
quimdel@hotmail.com

Horarios
Lunes a viernes
8:00A.M. – 5:00P.M.
Estamos para resolver sus inquietudes
Le invitamos a diligenciar sus datos en el siguiente formulario y nos comunicaremos con usted para atender su solicitud en el menor tiempo posible.


